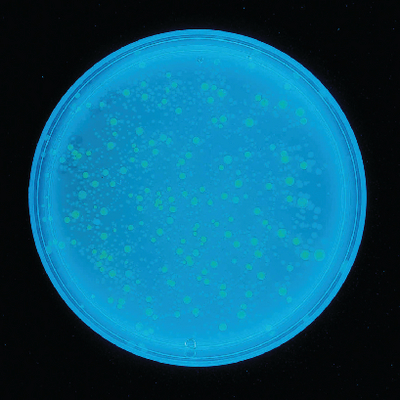

Transformation/E Coli,Green & Blue Fluor, Kit Of 1
$ 168.91
|
|
Details:
Transformation/E Coli,Green & Blue Fluor
Additional Information
| SKU | 23297045 |
|---|---|
| UOM | Kit of 1 |
| UNSPSC | 60100000 |
| Manufacturer Part Number | 222 |
| Product Dimensions | 13.2X10.4X3.1 Inches |
| Product Weight | 3.1 |
